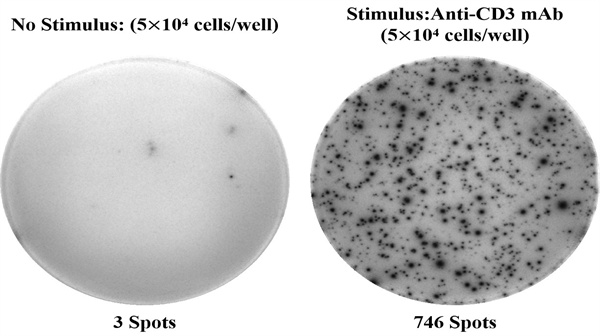
新闻图片1

武汉伊莱瑞特生物科技股份有限公司品牌商
12 年
手机商铺
- NaN
- 0.7999999999999998
- 0.7999999999999998
- 2.8
- 2.8
推荐产品
公司新闻/正文
Elabscience人IL-2(白介素2)ELISPOT试剂盒——单细胞水平精准分析免疫应答!
318 人阅读发布时间:2025-07-08 11:51
内容概要
Elabscience® 人白介素2(IL-2)酶联免疫斑点检测试剂盒(货号:ESP-H0006) 是一款高灵敏度、高特异性的ELISPOT检测工具,适用于单细胞水平分析IL-2分泌细胞频率,助力免疫学研究、疫苗开发、肿瘤免疫治疗评估等领域!
产品介绍
-
品牌:Elabscience®(武汉伊莱瑞特生物科技)
-
货号:ESP-H0006
-
规格:96T / 96T×5
-
样本类型:悬浮细胞(如PBMC、T细胞等)
-
储存条件:2-8℃
-
有效期:12个月
人IL-2(白介素2)ELISPOT试剂盒采用双抗体夹心法,结合PVDF膜包被技术,可精准检测极低浓度的IL-2分泌细胞,灵敏度高达百万分之一,适用于免疫功能性研究及动态监测!
检测原理
人IL-2(白介素2)ELISPOT试剂盒是基于双抗夹心法原理,用抗人IL-2抗体包被于微孔板底部PVDF膜上,实验时加入细胞悬液和刺激剂,细胞在培养过程中分泌的人IL-2会与包被抗体结合。通过洗涤除去细胞和未结合的物质,依次加入生物素化的抗人IL-2抗体和碱性磷酸酶标记的亲和素。生物素化的抗人IL-2抗体与结合在包被抗体上的人IL-2结合、生物素与亲和素特异性结合而形成免疫复合物,游离的成分被洗去。加入显色底物(BCIP/NBT),BCIP在碱性磷酸酶的催化下水解并与NBT发生反应,形成不溶性的深蓝色至蓝紫色斑点。用专业的ELISPOT读板仪软件分析,计算分泌人IL-2的细胞频率。
应用领域
✔ 免疫学研究:T细胞、NK细胞功能评估
✔ 疫苗开发:抗原特异性免疫应答检测
✔ 肿瘤免疫治疗:CAR-T、PD-1/PD-L1疗法效果监测
✔ 自身免疫疾病:Th1/Th2细胞因子谱分析
✔ 感染免疫:病毒/细菌特异性T细胞反应检测
产品优势
✅ 超高灵敏度——单细胞水平检测,低至1/1,000,000的分泌细胞
✅ 高特异性——无交叉反应,背景低,数据可靠
✅ 稳定重复——板内/板间CV <10%,确保实验结果一致性
✅ 操作便捷——3.5小时完成实验,适配自动化分析
✅ 全球认可——ISO9001 & CE认证,文献引用超21,818篇
Elabscience® 人IL-2(白介素2)ELISPOT试剂盒凭借其超高灵敏度、稳定可靠的性能,成为免疫学基础研究和疫苗开发的理想选择!无论是探索T细胞功能、评估抗原特异性免疫应答,还是优化实验方案,IL-2 ELISPOT试剂盒都能提供精准、可重复的数据,助力您的科研突破!


![FITC Anti-Mouse CD3 Antibody流式抗体[17A2]](https://img1.dxycdn.com/p/s14/2025/0609/471/0481799173518002391.png!wh200)
![FITC 标记抗小鼠/人 CD11b 抗体-流式抗体[M1/70]_货号:E-AB-F1081C](https://img1.dxycdn.com/p/s14/2025/0609/740/6904673901537002391.png!wh200)